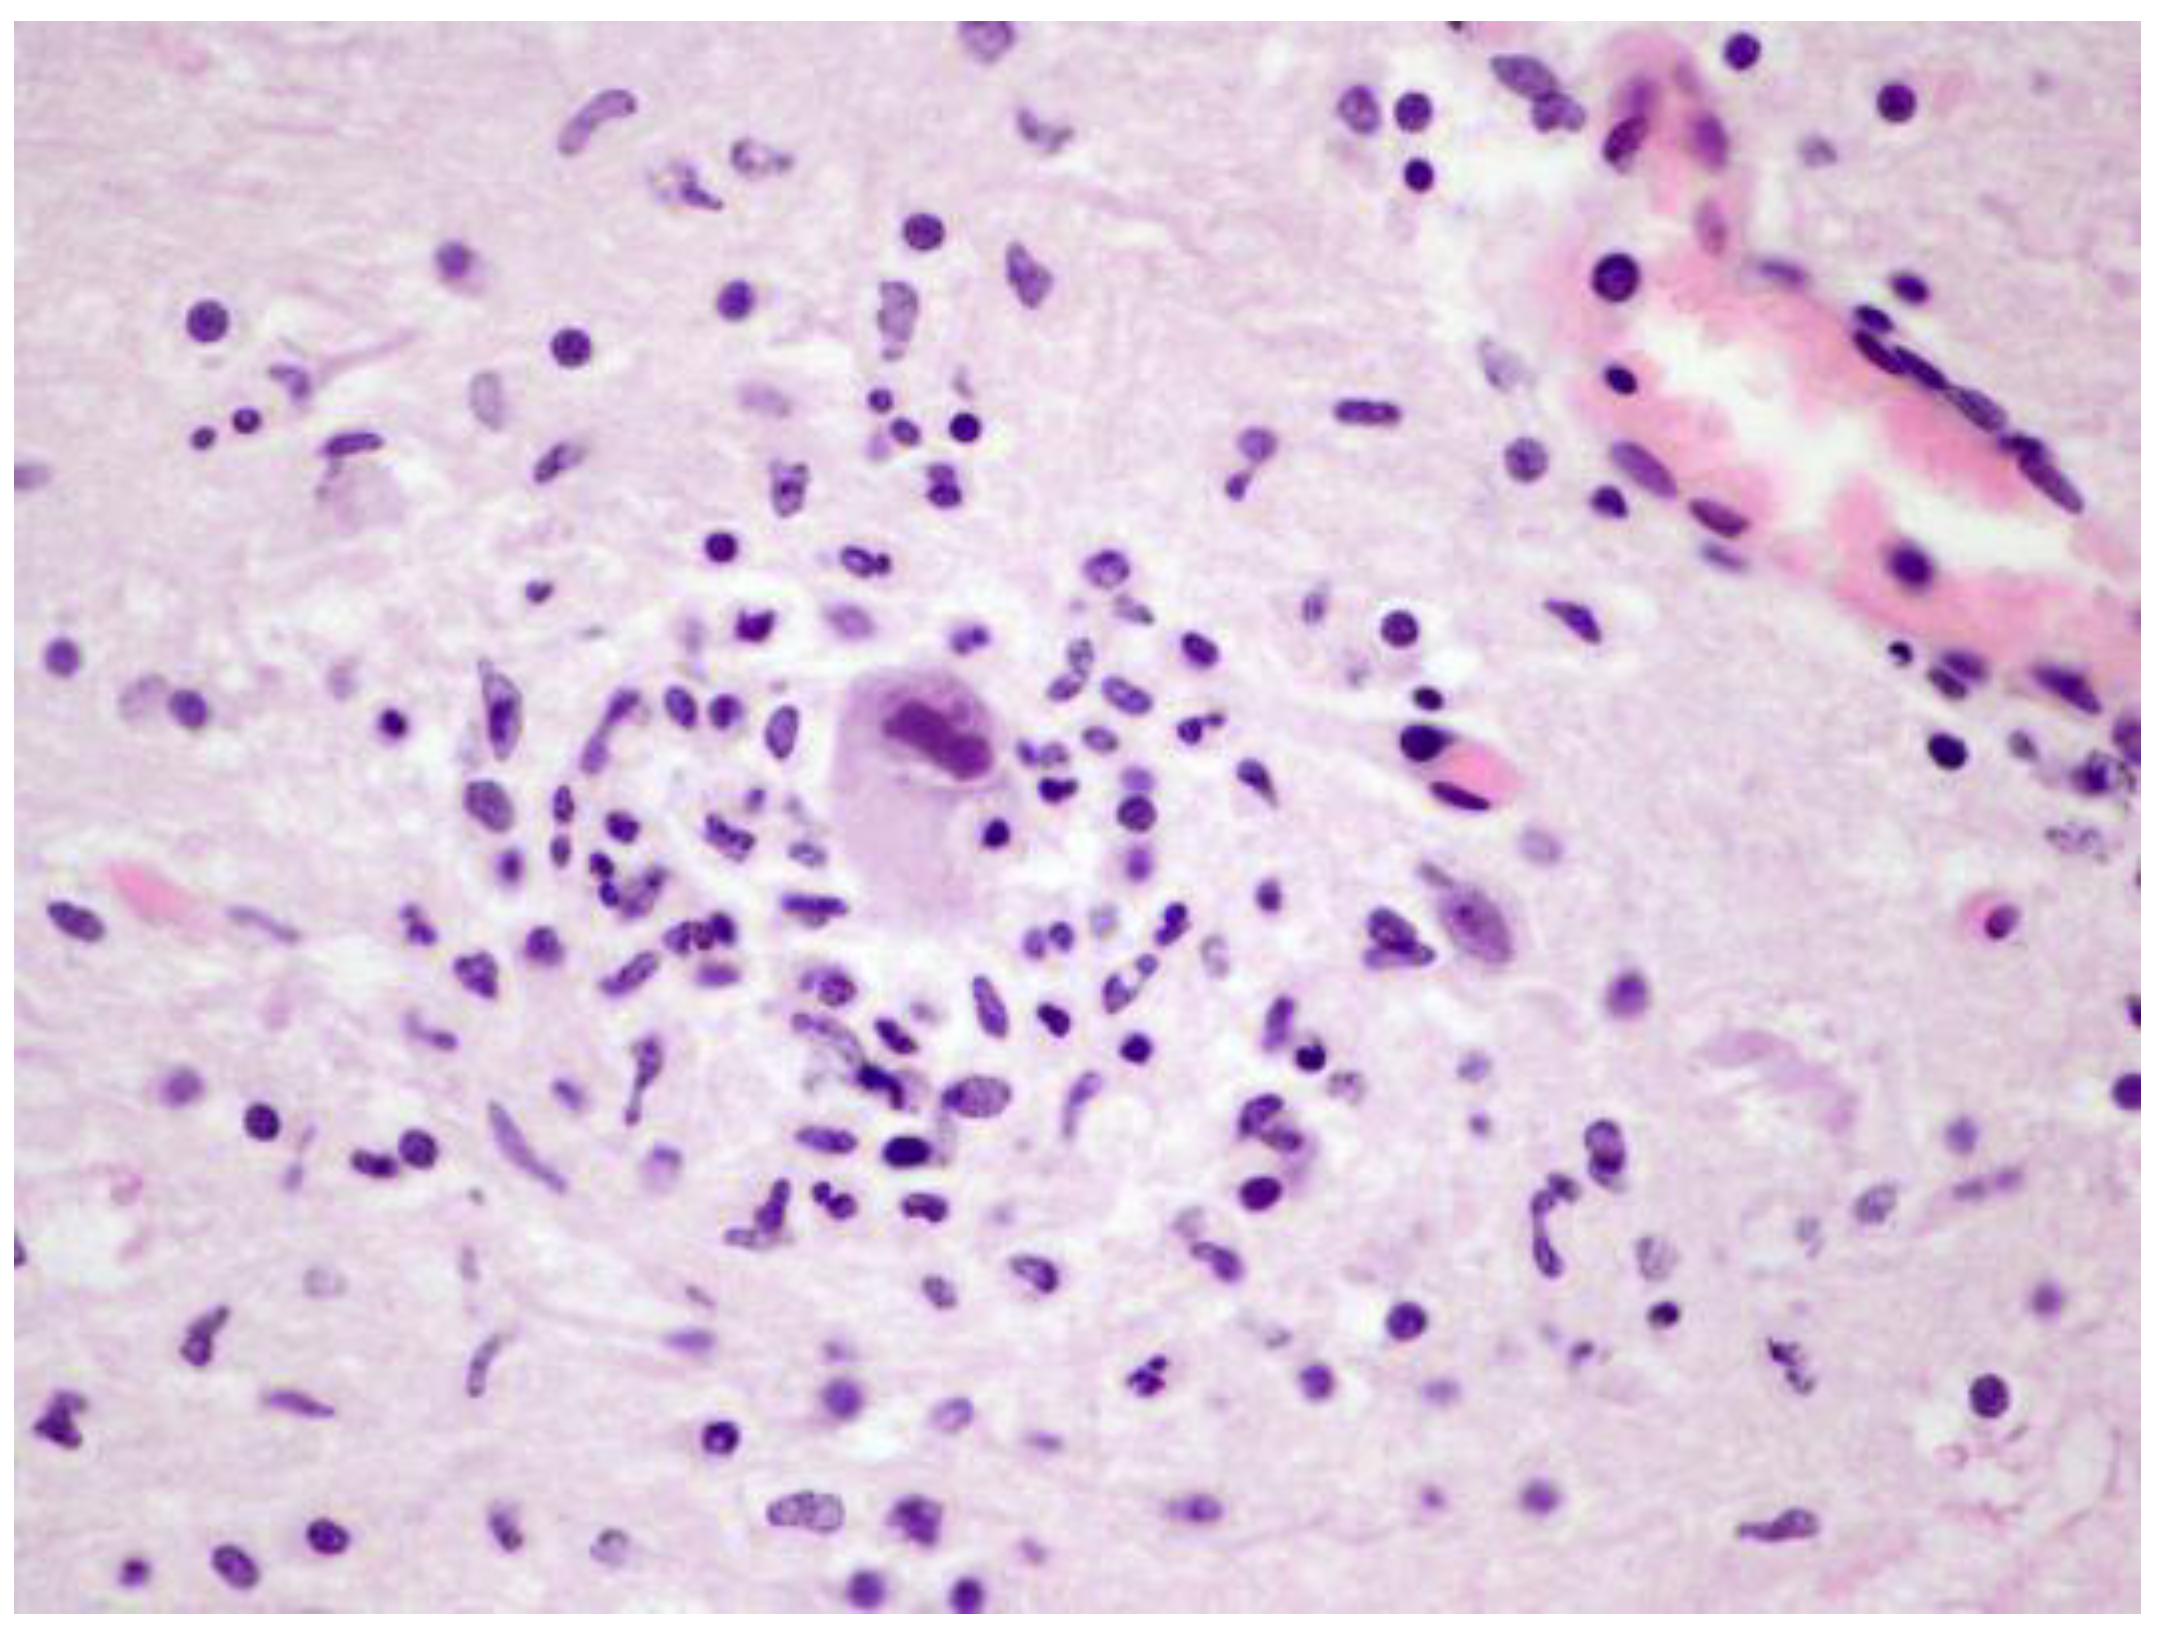
Animals 12 01149 g004

Molecular Characterization of Herpesviral Encephalitis in Cetaceans: Correlation with Histopathological and Immunohistochemical Findings
Abstract
:Simple Summary
Abstract
1. Introduction
2. Materials and Methods
2.1. Evidence of Ethical Approval
2.2. Animals, Necropsies, and Tissue Sampling
2.3. Histopathological Study
2.4. Molecular Virological Analyses
2.5. Immunohistochemical Analyses
3. Results
3.1. Molecular Results
3.2. Histopathological Findings and Virus Strains
3.3. q-PCR Results
3.4. Presence of HVs in Other Tissue Samples
3.5. Immunohistochemical Findings
3.6. Phylogenetic Tree
4. Discussion
5. Conclusions
Supplementary Materials
Author Contributions
Funding
Institutional Review Board Statement
Informed Consent Statement
Data Availability Statement
Acknowledgments
Conflicts of Interest
References
- Sehrawat, S.; Kumar, D.; Rouse, B.T. Herpesviruses: Harmonious Pathogens but Relevant Cofactors in Other Diseases? Front. Cell. Infect. Microbiol. 2018, 8, 177. [Google Scholar] [CrossRef] [PubMed]
- Honess, R.W.; Watson, D.H. Unity and diversity in the herpesviruses. J. Gen. Virol. 1977, 37, 15–37. [Google Scholar] [CrossRef] [PubMed]
- Fawl, R.L.; Roizman, B. The molecular basis of herpes simplex virus pathogenicity. Semin. Virol. 1994, 5, 261–271. [Google Scholar] [CrossRef]
- Hanson, L.; Dishon, A.; Kotler, M. Herpesviruses that infect fish. Viruses 2011, 3, 2160–2191. [Google Scholar] [CrossRef] [Green Version]
- Dortmans, J.C.; Koch, G.; Rottier, P.J.; Peeters, B.P. Virulence of Newcastle disease virus: What is known so far? Vet. Res. 2011, 42, 122. [Google Scholar] [CrossRef] [Green Version]
- Martineau, D.; Lagace, A.; Beland, P.; Higgins, R.; Armstrong, D.; Shugart, L.R. Pathology of stranded beluga whales (Delphinapterus leucas) from the St. Lawrence Estuary, Quebec, Canada. J. Comp. Pathol. 1988, 98, 287–311. [Google Scholar] [CrossRef]
- Smolarek Benson, K.A.; Manire, C.A.; Ewing, R.Y.; Saliki, J.T.; Townsend, F.I.; Ehlers, B.; Romero, C.H. Identification of novel alpha- and gammaherpesviruses from cutaneous and mucosal lesions of dolphins and whales. J. Virol. Methods 2006, 136, 261–266. [Google Scholar] [CrossRef]
- Arbelo, M.; Sierra, E.; Esperon, F.; Watanabe, T.T.; Belliere, E.N.; Espinosa de los Monteros, A.; Fernandez, A. Herpesvirus infection with severe lymphoid necrosis affecting a beaked whale stranded in the Canary Islands. Dis. Aquat. Organ. 2010, 89, 261–264. [Google Scholar] [CrossRef] [Green Version]
- Arbelo, M.; Belliere, E.N.; Sierra, E.; Sacchinni, S.; Esperon, F.; Andrada, M.; Rivero, M.; Diaz-Delgado, J.; Fernandez, A. Herpes virus infection associated with interstitial nephritis in a beaked whale (Mesoplodon densirostris). BMC Vet. Res. 2012, 8, 243. [Google Scholar] [CrossRef] [Green Version]
- van Beurden, S.J.; LL, I.J.; Ordonez, S.R.; Forster, C.; de Vrieze, G.; Grone, A.; Verheije, M.H.; Kik, M. Identification of a novel gammaherpesvirus associated with (muco)cutaneous lesions in harbour porpoises (Phocoena phocoena). Arch. Virol. 2015, 160, 3115–3120. [Google Scholar] [CrossRef]
- van Elk, C.; van de Bildt, M.; van Run, P.; de Jong, A.; Getu, S.; Verjans, G.; Osterhaus, A.; Kuiken, T. Central nervous system disease and genital disease in harbor porpoises (Phocoena phocoena) are associated with different herpesviruses. Vet. Res. 2016, 47, 28. [Google Scholar] [CrossRef] [PubMed] [Green Version]
- Miyoshi, K.; Nishida, S.; Sone, E.; Tajima, Y.; Makara, M.; Yoshioka, M.; Nakamura, M.; Yamada, T.K.; Koike, H. Molecular identification of novel alpha- and gammaherpesviruses from cetaceans stranded on Japanese coasts. Zool. Sci 2011, 28, 126–133. [Google Scholar] [CrossRef] [PubMed]
- Sacristan, C.; Esperon, F.; Ewbank, A.C.; Diaz-Delgado, J.; Ferreira-Machado, E.; Costa-Silva, S.; Sanchez-Sarmiento, A.M.; Groch, K.R.; Neves, E.; Pereira Dutra, G.H.; et al. Novel herpesviruses in riverine and marine cetaceans from South America. Acta Trop. 2019, 190, 220–227. [Google Scholar] [CrossRef] [PubMed]
- Exposto Novoselecki, H.; Catão-Dias, J.L.; Ewbank, A.C.; Navas-Suárez, P.E.; Duarte-Benvenuto, A.; Lial, H.C.; Costa Silva, S.; Sánchez-Sarmiento, A.M.; Gravena, W.; da Silva, V.M.F.; et al. Highly divergent herpesviruses in threatened river dolphins from Brazil. Sci. Rep. 2021, 11, 24528. [Google Scholar] [CrossRef] [PubMed]
- Melero, M.; Crespo-Picazo, J.L.; Rubio-Guerri, C.; Garcia-Parraga, D.; Sanchez-Vizcaino, J.M. First molecular determination of herpesvirus from two mysticete species stranded in the Mediterranean Sea. BMC Vet. Res. 2015, 11, 015–0596. [Google Scholar] [CrossRef] [PubMed]
- Soto, S.; Gonzalez, B.; Willoughby, K.; Maley, M.; Olvera, A.; Kennedy, S.; Marco, A.; Domingo, M. Systemic Herpesvirus and Morbillivirus Co-Infection in a Striped Dolphin (Stenella coeruleoalba). J. Comp. Pathol. 2012, 146, 269–273. [Google Scholar] [CrossRef]
- Sierra, E.; Sanchez, S.; Saliki, J.T.; Blas-Machado, U.; Arbelo, M.; Zucca, D.; Fernandez, A. Retrospective study of etiologic agents associated with nonsuppurative meningoencephalitis in stranded cetaceans in the canary islands. J. Clin. Microbiol. 2014, 52, 2390–2397. [Google Scholar] [CrossRef] [Green Version]
- Blanchard, T.W.; Santiago, N.T.; Lipscomb, T.P.; Garber, R.L.; McFee, W.E.; Knowles, S. Two novel alphaherpesviruses associated with fatal disseminated infections in Atlantic bottlenose dolphins. J. Wildl. Dis. 2001, 37, 297–305. [Google Scholar] [CrossRef] [Green Version]
- Bento, M.C.; Canha, R.; Eira, C.; Vingada, J.; Nicolau, L.; Ferreira, M.; Domingo, M.; Tavares, L.; Duarte, A. Herpesvirus infection in marine mammals: A retrospective molecular survey of stranded cetaceans in the Portuguese coastline. Infect. Genet. Evol. 2019, 67, 222–233. [Google Scholar] [CrossRef]
- Lecis, R.; Tocchetti, M.; Rotta, A.; Naitana, S.; Ganges, L.; Pittau, M.; Alberti, A. First Gammaherpesvirus detection in a free-living Mediterranean bottlenose dolphin. J. Zoo Wildl. Med. 2014, 45, 922–925. [Google Scholar] [CrossRef]
- Bellehumeur, C.; Lair, S.; Romero, C.H.; Provost, C.; Nielsen, O.; Gagnon, C.A. Identification of a Novel Herpesvirus Associated with a Penile Proliferative Lesion in a Beluga (Delphinapterus leucas). J. Wildl. Dis. 2015, 51, 244–249. [Google Scholar] [CrossRef] [PubMed] [Green Version]
- Saliki, J.T.; Cooper, E.J.; Rotstein, D.S.; Caseltine, S.L.; Pabst, D.A.; McLellan, W.A.; Govett, P.; Harms, C.; Smolarek, K.A.; Romero, C.H. A novel gammaherpesvirus associated with genital lesions in a Blainville’s beaked whale (Mesoplodon densirostris). J. Wildl. Dis. 2006, 42, 142–148. [Google Scholar] [CrossRef] [PubMed] [Green Version]
- Sierra, E.; Diaz-Delgado, J.; Arbelo, M.; Andrada, M.; Sacchini, S.; Fernandez, A. Herpesvirus-Associated Genital Lesions in a Stranded Striped Dolphin (Stenella Coeruleoalba) in the Canary Islands, Spain. J. Wildl. Dis. 2015, 51, 696–702. [Google Scholar] [CrossRef] [PubMed]
- Seade, G.C.C.; Cerqueira, V.D.; Sierra, E.; Chaves, J.F.; Moura, M.A.O.; Montao, D.P.; Riet-Correa, G.; Oliveira, C.A.; Siciliano, S.; Emin-Lima, R.; et al. Herpesviral infection in a Guiana dolphin (Sotalia guianensis) from the northern coast of Brazil. J. Vet. Diagn. Investig. 2017, 29, 877–879. [Google Scholar] [CrossRef] [PubMed] [Green Version]
- Kennedy, S.; Lindstedt, I.J.; McAliskey, M.M.; McConnell, S.A.; McCullough, S.J. Herpesviral encephalitis in a harbor porpoise (Phocoena phocoena). J. Zoo Wildl. Med. 1992, 23, 374–379. [Google Scholar]
- Esperon, F.; Fernandez, A.; Sanchez-Vizcaino, J.M. Herpes simplex-like infection in a bottlenose dolphin stranded in the Canary Islands. Dis. Aquat. Organ. 2008, 81, 73–76. [Google Scholar] [CrossRef] [Green Version]
- Sierra, E.; Fernández, A.; Felipe-Jiménez, I.; Zucca, D.; Díaz-Delgado, J.; Puig-Lozano, R.; Câmara, N.; Consoli, F.; Díaz-Santana, P.; Suárez-Santana, C.; et al. Histopathological Differential Diagnosis of Meningoencephalitis in Cetaceans: Morbillivirus, Herpesvirus, Toxoplasma gondii, Brucella sp., and Nasitrema sp. Front. Vet. Sci. 2020, 7, 650. [Google Scholar] [CrossRef]
- Bellière, E.N.; Esperon, F.; Arbelo, M.; Munoz, M.J.; Fernandez, A.; Sanchez-Vizcaino, J.M. Presence of herpesvirus in striped dolphins stranded during the cetacean morbillivirus epizootic along the Mediterranean Spanish coast in 2007. Arch. Virol. 2010, 155, 1307–1311. [Google Scholar] [CrossRef]
- Vargas-Castro, I.; Crespo-Picazo, J.L.; Rivera-Arroyo, B.; Sánchez, R.; Marco-Cabedo, V.; Jiménez-Martínez, M.; Fayos, M.; Serdio, Á.; García-Párraga, D.; Sánchez-Vizcaíno, J.M. Alpha- and gammaherpesviruses in stranded striped dolphins (Stenella coeruleoalba) from Spain: First molecular detection of gammaherpesvirus infection in central nervous system of odontocetes. BMC Vet. Res. 2020, 16, 288. [Google Scholar] [CrossRef]
- Vargas-Castro, I.; Melero, M.; Crespo-Picazo, J.L.; Jiménez, M.; Sierra, E.; Rubio-Guerri, C.; Arbelo, M.; Fernández, A.; García-Párraga, D.; Sánchez-Vizcaíno, J.M. Systematic Determination of Herpesvirus in Free-Ranging Cetaceans Stranded in the Western Mediterranean: Tissue Tropism and Associated Lesions. Viruses 2021, 13, 2180. [Google Scholar] [CrossRef]
- Melero, M.; Rubio-Guerri, C.; Crespo, J.L.; Garcia-Parraga, D.; Sanchez-Vizcaino, J.M. Herpesvirus determination in free-ranging cetaceans stranded in the Mediterranean sea between June 2010 and June 2013. In Proceedings of the 46th Annual IAAAM Meeting and Conference, International Association for Aquatic Animal Medicine, Chicago, IL, USA, 6–10 April 2015. [Google Scholar]
- Felipe-Jiménez, I.; Fernández, A.; Andrada, M.; Arbelo, M.; Segura-Göthlin, S.; Colom-Rivero, A.; Sierra, E. Contribution to Herpesvirus Surveillance in Beaked Whales Stranded in the Canary Islands. Animals 2021, 11, 1923. [Google Scholar] [CrossRef] [PubMed]
- Kuiken, T.; García Hartmann, M. Cetacean pathology: Dissection techniques and tissue sampling. In Proceedings of the First ECS Workshop on Cetacean Pathology. ECS Newsletter 17—Special Issue. European Cetacean Society 1991, Leiden, The Netherlands, 13–14 September 1991; pp. 1–39. [Google Scholar]
- Arbelo, M.; Los Monteros, A.E.; Herraez, P.; Andrada, M.; Sierra, E.; Rodriguez, F.; Jepson, P.D.; Fernandez, A. Pathology and causes of death of stranded cetaceans in the Canary Islands (1999-2005). Dis. Aquat. Organ. 2013, 103, 87–99. [Google Scholar] [CrossRef] [PubMed]
- Díaz-Delgado, J.; Fernández, A.; Sierra, E.; Sacchini, S.; Andrada, M.; Vela, A.I.; Quesada-Canales, Ó.; Paz, Y.; Zucca, D.; Groch, K.; et al. Pathologic findings and causes of death of stranded cetaceans in the Canary Islands (2006–2012). PLoS ONE 2018, 13, e0204444. [Google Scholar] [CrossRef] [Green Version]
- Ijsseldijk, L.L.; Brownlow, A.C.; Mazzariol, S. Best practice on cetacean post mortem investigation and tissue sampling. Jt. ACCOBAMS ASCOBANS Doc. 2019, 1–73. [Google Scholar]
- Sacchini, S.; Herráez, P.; Arbelo, M.; Espinosa de Los Monteros, A.; Sierra, E.; Rivero, M.; Bombardi, C.; Fernández, A. Methodology and Neuromarkers for Cetaceans’ Brains. Vet. Sci. 2022, 9, 38. [Google Scholar] [CrossRef]
- Sacristan, C.; Carballo, M.; Munoz, M.J.; Belliere, E.N.; Neves, E.; Nogal, V.; Esperon, F. Diagnosis of Cetacean morbillivirus: A sensitive one step real time RT fast-PCR method based on SYBR® Green. J. Virol. Methods 2015, 226, 25–30. [Google Scholar] [CrossRef]
- VanDevanter, D.R.; Warrener, P.; Bennett, L.; Schultz, E.R.; Coulter, S.; Garber, R.L.; Rose, T.M. Detection and analysis of diverse herpesviral species by consensus primer PCR. J. Clin. Microbiol. 1996, 34, 1666–1671. [Google Scholar] [CrossRef] [Green Version]
- Kumar, S.; Stecher, G.; Li, M.; Knyaz, C.; Tamura, K. MEGA X: Molecular evolutionary genetics analysis across computing platforms. Mol. Biol. Evol. 2018, 35, 1547–1549. [Google Scholar] [CrossRef]
- Reidarson, T.H.; McBain, J.; House, C.; King, D.P.; Stott, J.L.; Krafft, A.; Taubenberger, J.K.; Heyning, J.; Lipscomb, T.P. Morbillivirus infection in stranded common dolphins from the Pacific Ocean. J. Wildl. Dis. 1998, 34, 771–776. [Google Scholar] [CrossRef]
- Groch, K.R.; Taniwaki, S.A.; Favero, C.M.; Brandão, P.E.; Díaz-Delgado, J.; Fernández, A.; Catão-Dias, J.L.; Sierra, E. A novel real-time PCR to detect Cetacean morbillivirus in Atlantic cetaceans. J. Virol. Methods 2020, 285, 113964. [Google Scholar] [CrossRef]
- Elizalde, M.; Cano-Gómez, C.; Llorente, F.; Pérez-Ramírez, E.; Casades-Martí, L.; Aguilera-Sepúlveda, P.; Ruiz-Fons, F.; Jiménez-Clavero, M.; Fernández-Pinero, J. A Duplex Quantitative Real-Time Reverse Transcription-PCR for Simultaneous Detection and Differentiation of Flaviviruses of the Japanese Encephalitis and Ntaya Serocomplexes in Birds. Front. Vet. Sci. 2020, 7, 203. [Google Scholar] [CrossRef] [PubMed]
- Moureau, G.; Temmam, S.; Gonzalez, J.P.; Charrel, R.N.; Grard, G.; de Lamballerie, X. A real-time RT-PCR method for the universal detection and identification of flaviviruses. Vector-Borne Zoonotic Dis. 2007, 7, 467–477. [Google Scholar] [CrossRef] [PubMed]
- Wu, Q.; McFee, W.E.; Goldstein, T.; Tiller, R.V.; Schwacke, L. Real-time PCR assays for detection of Brucella spp. and the identification of genotype ST27 in bottlenose dolphins (Tursiops truncatus). J. Microbiol. Methods 2014, 100, 99–104. [Google Scholar] [CrossRef] [PubMed]
- Groch, K.R.; Díaz-Delgado, J.; Santos-Neto, E.B.; Ikeda, J.M.P.; Carvalho, R.R.; Oliveira, R.B.; Guari, E.B.; Flach, L.; Sierra, E.; Godinho, A.I.; et al. The Pathology of Cetacean Morbillivirus Infection and Comorbidities in Guiana Dolphins During an Unusual Mortality Event (Brazil, 2017-2018). Vet. Pathol. 2020, 57, 845–857. [Google Scholar] [CrossRef] [PubMed]
- Sierra, E.; Fernández, A.; Zucca, D.; Câmara, N.; Felipe-Jiménez, I.; Suárez-Santana, C.; de Quirós, Y.B.; Díaz-Delgado, J.; Arbelo, M. Morbillivirus infection in Risso’s dolphin Grampus griseus: A phylogenetic and pathological study of cases from the Canary Islands. Dis. Aquat. Organ. 2018, 129, 165–174. [Google Scholar] [CrossRef] [PubMed]
- Deudero, S.; Alomar, C. Mediterranean marine biodiversity under threat: Reviewing influence of marine litter on species. Mar. Pollut. Bull. 2015, 98, 58–68. [Google Scholar] [CrossRef]
- Van Bressem, M.F.; Raga, J.A.; Di Guardo, G.; Jepson, P.D.; Duignan, P.J.; Siebert, U.; Barrett, T.; Santos, M.C.; Moreno, I.B.; Siciliano, S.; et al. Emerging infectious diseases in cetaceans worldwide and the possible role of environmental stressors. Dis. Aquat. Organ. 2009, 86, 143–157. [Google Scholar] [CrossRef]
- Bossart, G.D. Marine mammals as sentinel species for oceans and human health. Braund K. G. 2011, 48, 676–690. [Google Scholar] [CrossRef] [Green Version]
- Van Bressem, M.F.; Duignan, P.J.; Banyard, A.; Barbieri, M.; Colegrove, K.M.; De Guise, S.; Di Guardo, G.; Dobson, A.; Domingo, M.; Fauquier, D.; et al. Cetacean morbillivirus: Current knowledge and future directions. Viruses 2014, 6, 5145–5181. [Google Scholar] [CrossRef]
- Grattarola, C.; Giorda, F.; Iulini, B.; Pautasso, A.; Ballardini, M.; Zoppi, S.; Marsili, L.; Peletto, S.; Masoero, L.; Varello, K.; et al. Occlusive mycotic tracheobronchitis and systemic Alphaherpesvirus coinfection in a free-living striped dolphin Stenella coeruleoalba in Italy. Dis. Aquat. Organ. 2018, 127, 137–144. [Google Scholar] [CrossRef]
- Maness, H.T.; Nollens, H.H.; Jensen, E.D.; Goldstein, T.; LaMere, S.; Childress, A.; Sykes, J.; St Leger, J.; Lacave, G.; Latson, F.E.; et al. Phylogenetic analysis of marine mammal herpesviruses. Vet. Microbiol. 2011, 149, 23–29. [Google Scholar] [CrossRef] [PubMed]
- Koyuncu, O.O.; Hogue, I.B.; Enquist, L.W. Virus infections in the nervous system. Cell Host Microbe 2013, 13, 379–393. [Google Scholar] [CrossRef] [PubMed] [Green Version]
- Chan, P.K.; Ng, H.K.; Hui, M.; Ip, M.; Cheung, J.L.; Cheng, A.F. Presence of human herpesviruses 6, 7, and 8 DNA sequences in normal brain tissue. J. Med. Virol. 1999, 59, 491–495. [Google Scholar] [CrossRef]
- Chan, P.K.; Ng, H.K.; Cheung, J.L.; Cheng, A.F. Survey for the presence and distribution of human herpesvirus 8 in healthy brain. J. Clin. Microbiol. 2000, 38, 2772–2773. [Google Scholar] [CrossRef] [Green Version]
- Karatas, H.; Gurer, G.; Pinar, A.; Soylemezoglu, F.; Tezel, G.G.; Hascelik, G.; Akalan, N.; Tuncer, S.; Ciger, A.; Saygi, S. Investigation of HSV-1, HSV-2, CMV, HHV-6 and HHV-8 DNA by real-time PCR in surgical resection materials of epilepsy patients with mesial temporal lobe sclerosis. J. Neurol. Sci. 2008, 264, 151–156. [Google Scholar] [CrossRef] [PubMed]
- Bossolasco, S.; Falk, K.I.; Ponzoni, M.; Ceserani, N.; Crippa, F.; Lazzarin, A.; Linde, A.; Cinque, P. Ganciclovir is associated with low or undetectable Epstein-Barr virus DNA load in cerebrospinal fluid of patients with HIV-related primary central nervous system lymphoma. Clin. Infect. Dis. 2006, 42, e21–e25. [Google Scholar] [CrossRef] [PubMed] [Green Version]
- Said, J.W.; Tasaka, T.; de Vos, S.; Koeffler, H.P. Kaposi’s sarcoma-associated herpesvirus/human herpesvirus type 8 encephalitis in HIV-positive and -negative individuals. AIDS 1997, 11, 1119–1122. [Google Scholar] [CrossRef]
- Serafini, B.; Rosicarelli, B.; Franciotta, D.; Magliozzi, R.; Reynolds, R.; Cinque, P.; Andreoni, L.; Trivedi, P.; Salvetti, M.; Faggioni, A.; et al. Dysregulated Epstein-Barr virus infection in the multiple sclerosis brain. J. Exp. Med. 2007, 204, 2899–2912. [Google Scholar] [CrossRef]
- Yamada, S.; Kameyama, T.; Nagaya, S.; Hashizume, Y.; Yoshida, M. Relapsing herpes simplex encephalitis: Pathological confirmation of viral reactivation. J. Neurol. Neurosurg. Psychiatry 2003, 74, 262–264. [Google Scholar] [CrossRef] [Green Version]
- Stenvers, O.; Zhang, X.M.; Ludwig, H. Herpesvirus infections in seals: A summary of present knowledge. Rev. Sci. Tech. 1992, 11, 1151–1154. [Google Scholar] [CrossRef] [Green Version]
- Raga, J.A.; Banyard, A.; Domingo, M.; Corteyn, M.; Van Bressem, M.F.; Fernandez, M.; Aznar, F.J.; Barrett, T. Dolphin morbillivirus epizootic resurgence, Mediterranean Sea. Emerg. Infect. Dis. 2008, 14, 471–473. [Google Scholar] [CrossRef] [PubMed]
- Bento, M.C.; Eira, C.I.; Vingada, J.V.; Marçalo, A.L.; Ferreira, M.C.; Fernandez, A.L.; Tavares, L.M.; Duarte, A.I. New insight into dolphin morbillivirus phylogeny and epidemiology in the northeast Atlantic: Opportunistic study in cetaceans stranded along the Portuguese and Galician coasts. BMC Vet. Res. 2016, 12, 176. [Google Scholar] [CrossRef] [PubMed] [Green Version]
- Syverton, J.T.; Berry, G.P. Multiple virus infection of single host cells. J. Exp. Med. 1947, 86, 145–152. [Google Scholar] [CrossRef]
- Karpf, A.R.; Lenches, E.; Strauss, E.G.; Strauss, J.H.; Brown, D.T. Superinfection exclusion of alphaviruses in three mosquito cell lines persistently infected with Sindbis virus. J. Virol. 1997, 71, 7119–7123. [Google Scholar] [CrossRef] [PubMed] [Green Version]
- Rubio-Guerri, C.; Melero, M.; Esperon, F.; Belliere, E.N.; Arbelo, M.; Crespo, J.L.; Sierra, E.; Garcia-Parraga, D.; Sanchez-Vizcaino, J.M. Unusual striped dolphin mass mortality episode related to cetacean morbillivirus in the Spanish Mediterranean Sea. BMC Vet. Res. 2013, 9, 106. [Google Scholar] [CrossRef] [PubMed] [Green Version]
- Padgett, D.A.; Sheridan, J.F.; Dorne, J.; Berntson, G.G.; Candelora, J.; Glaser, R. Social stress and the reactivation of latent herpes simplex virus type 1. Proc. Natl. Acad. Sci. USA 1998, 95, 7231–7235. [Google Scholar] [CrossRef] [Green Version]
- Nugent, J.; Birch-Machin, I.; Smith, K.C.; Mumford, J.A.; Swann, Z.; Newton, J.R.; Bowden, R.J.; Allen, G.P.; Davis-Poynter, N. Analysis of equid herpesvirus 1 strain variation reveals a point mutation of the DNA polymerase strongly associated with neuropathogenic versus nonneuropathogenic disease outbreaks. J. Virol. 2006, 80, 4047–4060. [Google Scholar] [CrossRef] [Green Version]
- Tregoning, J.S.; Schwarze, J. Respiratory viral infections in infants: Causes, clinical symptoms, virology, and immunology. Clin. Microbiol. Rev. 2010, 23, 74–98. [Google Scholar] [CrossRef] [Green Version]

| Case No. | Lab Reference | Species | Sex | AC | SD | SP | CC |
|---|---|---|---|---|---|---|---|
| 1 | I-086/01 (CET 124) | Tursiops truncatus | M | A | 11/04/2001 | Tenerife (Canary Islands) | Fresh |
| 2 | I-091/07 (CET 380) | Stenella coeruleoalba | M | J | 16/04/2007 | Tenerife (Canary Islands) | Fresh |
| 3 | I-145/11 (CET 574) | Stenella coeruleoalba | M | J | 01/05/2011 | Gran Canaria (Canary Islands) | Fresh |
| 4 | I-289/13 (NA) | Stenella coeruleoalba | M | C | 31/08/2013 | Cádiz (Andalusia) | Moderate autolysis |
| 5 | I-151/14 (CET 717) | Stenella coeruleoalba | M | J | 21/05/2014 | Gran Canaria (Canary Islands) | Very fresh |
| 6 | I-416/15 (CET 772) | Stenella coeruleoalba | F | A | 21/08/2015 | Lanzarote (Canary Islands) | Fresh |
| 7 | I-08/16 (NA) | Ziphius cavirostris | M | A | 02/12/2015 | Huelva (Andalusia) | Moderate autolysis |
| 8 | I-287/16 (CET 798) | Stenella frontalis | M | A | 08/04/2016 | Tenerife (Canary Islands) | Fresh |
| 9 | I-907/16 (CET 810) | Delphinus delphis | F | J | 03/07/2016 | Tenerife (Canary Islands) | Fresh |
| 10 | I-167/17 (CET 854) | Stenella frontalis | F | J | 15/05/2017 | Tenerife (Canary Islands) | Moderate autolysis |
| 11 | SA038/18 (CET 884) | Stenella frontalis | F | C | 16/01/2018 | Tenerife (Canary Islands) | Fresh |
| 12 | SA223/18 (CET 921) | Stenella coeruleoalba | M | J | 05/07/2018 | Gran Canaria (Canary Islands) | Moderate autolysis |
| C. N° | CNS Lesions | GenBank Acc. No. | N.I. | qPCR | qPCR | IHQ | ||||||||
|---|---|---|---|---|---|---|---|---|---|---|---|---|---|---|
| Me | PC | M | INIB | Ma | NNs | H | OL | C-I | Ct | mTª | ||||
| 1 | - | X | X | - | - | - | - | - | - | EU003440 | 95.79% MN401208 (HSV-1) | NA | NA | - |
| 2 | X | X | X | - | - | X | - | - | DMV | KJ156330 | 99.45% GQ888669 (α) | NA | NA | - |
| 3 | X | X | X | X | X | X | X | - | - | KJ156331 | 99.49% KY680657(α) | 17.74 | 91 | + |
| 4 | X | X | X | X | X | X | X | - | - | KY680657 | 100% KY680656(α) | 7.32 | 90.50 | + |
| 5 | X | X | X | X | X | X | X | Choroiditis | - | KY680656 | 99.06% MN179658(α) | 23.31 | 90.00 | + |
| 6 | X | X | - | - | - | - | - | Choroiditis | - | OM030214 OM030215 | 93.46% KP995683 (α)99.38% KM248274 (γ) | 32.15 | 88.00 | - |
| 7 | - | - | - | - | - | - | - | - | - | KY680659 | 90.37% JN863234 (α) | 12.91 | 86.50 | - |
| 8 | - | X | X | - | - | - | X | Choroiditis | S. aureus | KY680658 | 91.79% MG437204 (α) | - | - | - |
| 9 | X | X | X | - | - | X | - | - | DMV | MN179655 | 99.02% MG437212 (α) | - | - | + |
| 10 | X | X | X | X | - | X | - | - | - | MN179656 | 91.4% MG4337212 (α) | 22.20 | 91.50 | + |
| 11 | X | X | X | X | X | X | - | - | Brucella spp. | MN179657 | 92.56% MG437213 (α) | 22.81 | 90.50 | + |
| 12 | X | X | X | X | X | X | X | Choroiditis, syncytia | DMV | MN179658 | 99.06% KY680656(α) | 12.66 | 90.50 | + |
| Case No. | Tissue Samples Analysed for HV in Animals with HV-Molecularly Positive Brains |
|---|---|
| 1 | Skeletal muscle, lung, liver, kidney, brain |
| 2 | Skin, skeletal muscle, lung, liver, kidney, brain, spleen |
| 3 | Skin, skeletal muscle, lung, liver, mesenteric lymph node, kidney, brain, spleen |
| 4 | Skin, skeletal muscle, lung, liver, mesenteric lymph node, kidney, brain, spleen |
| 5 | Skin, skeletal muscle, lung, liver, mesenteric lymph node, kidney, brain, spleen |
| 6 | Skin, skeletal muscle, lung, mesenteric lymph node, kidney, brain, spleen |
| 7 | liver, kidney, brain |
| 8 | lung, prescapular lymph node, intestine, brain, spleen |
| 9 | lung, prescapular lymph node, heart, intestine, brain, spleen |
| 10 | lung, prescapular lymph node, intestine, brain, spleen |
| 11 | Skin, skeletal muscle, lung, liver, mesenteric lymph node, kidney, brain, spleen |
| 12 | Skin, skeletal muscle, lung, liver, mesenteric lymph node, kidney, brain, spleen |
| Average Samples per Analysed Animals | Positive Animals | Positive Tissues | HV-Positive Animals (%) | HV-Positive Tissue Samples (%) | References |
|---|---|---|---|---|---|
| 178/79; 2.25 | 4 | 9 | 5.06% | 5% | Miyoshi et al., 2011 [12] |
| 446/103; 4.33 | 12 + 13 * = 25 | 40 | 24.3% | 8.9% | Our study |
| 294/55; 5.34 | 8 | 15 | 14.5% | 5.1% | Felipe-Jiménez et al., 2021 [32] |
| 182/14; 13 | 11 | 34 | 78.6% | 18.68% | Vargas Castro et al., 2020 [29] |
| 966/47; 20.25 | 38 | 121 | 80.85% | 12.5% | Vargas-Castro et al., 2021 [30] |
Publisher’s Note: MDPI stays neutral with regard to jurisdictional claims in published maps and institutional affiliations. |
© 2022 by the authors. Licensee MDPI, Basel, Switzerland. This article is an open access article distributed under the terms and conditions of the Creative Commons Attribution (CC BY) license (https://creativecommons.org/licenses/by/4.0/).
Share and Cite
Sierra, E.; Fernández, A.; Fernández-Maldonado, C.; Sacchini, S.; Felipe-Jiménez, I.; Segura-Göthlin, S.; Colom-Rivero, A.; Câmara, N.; Puig-Lozano, R.; Rambaldi, A.M.; et al. Molecular Characterization of Herpesviral Encephalitis in Cetaceans: Correlation with Histopathological and Immunohistochemical Findings. Animals 2022, 12, 1149. https://doi.org/10.3390/ani12091149
Sierra E, Fernández A, Fernández-Maldonado C, Sacchini S, Felipe-Jiménez I, Segura-Göthlin S, Colom-Rivero A, Câmara N, Puig-Lozano R, Rambaldi AM, et al. Molecular Characterization of Herpesviral Encephalitis in Cetaceans: Correlation with Histopathological and Immunohistochemical Findings. Animals. 2022; 12(9):1149. https://doi.org/10.3390/ani12091149
Chicago/Turabian StyleSierra, Eva, Antonio Fernández, Carolina Fernández-Maldonado, Simona Sacchini, Idaira Felipe-Jiménez, Simone Segura-Göthlin, Ana Colom-Rivero, Nakita Câmara, Raquel Puig-Lozano, Anna Maria Rambaldi, and et al. 2022. "Molecular Characterization of Herpesviral Encephalitis in Cetaceans: Correlation with Histopathological and Immunohistochemical Findings" Animals 12, no. 9: 1149. https://doi.org/10.3390/ani12091149
APA StyleSierra, E., Fernández, A., Fernández-Maldonado, C., Sacchini, S., Felipe-Jiménez, I., Segura-Göthlin, S., Colom-Rivero, A., Câmara, N., Puig-Lozano, R., Rambaldi, A. M., Suárez-Santana, C., & Arbelo, M. (2022). Molecular Characterization of Herpesviral Encephalitis in Cetaceans: Correlation with Histopathological and Immunohistochemical Findings. Animals, 12(9), 1149. https://doi.org/10.3390/ani12091149








